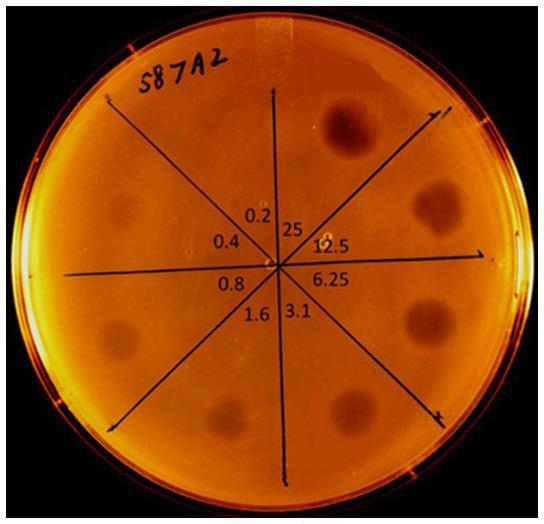

噬菌体溶菌酶成功用于治疗慢性盆腔疼痛综合征/慢性细菌性前列腺炎。
Successful use of a phage endolysin for treatment of chronic pelvic pain syndrome/chronic bacterial prostatitis.
作者信息
Stevens Roy H, Zhang Hongming, Kajsik Michal, Płoski Rafał, Rydzanicz Malgorzata, Sabaka Peter, Šutovský Stanislav
机构信息
Laboratory of Oral Infectious Diseases, Kornberg School of Dentistry, Temple University, Philadelphia, PA, United States.
Department of Bacteriology, Comenius University Science Park, Bratislava, Slovakia.
出版信息
Front Med (Lausanne). 2023 Aug 15;10:1238147. doi: 10.3389/fmed.2023.1238147. eCollection 2023.
Chronic prostatitis (CP) is a common inflammatory condition of the prostate that is estimated to effect 2%-10% of the world's male population. It can manifest as perineal, suprapubic, or lower back pain and urinary symptoms occurring with either recurrent bacterial infection [chronic bacterial prostatitis (CBP)] or in the absence of evidence of bacterial infection [chronic pelvic pain syndrome (CPPS)]. Here, in the case of a 39 years-old CBP patient, we report the first successful use of a bacteriophage-derived muralytic enzyme (endolysin) to treat and resolve the disease. Bacteriological analysis of the patient's prostatic secretion and semen samples revealed a chronic prostate infection, supporting a diagnosis of CBP. The patient's strain was resistant to several antibiotics and developed resistance to others during the course of treatment. Previous treatment with multiple courses of antibiotics, bacteriophages, probiotics, and immunologic stimulation had failed to achieve long term eradication of the infection or lasting mitigation of the symptoms. A cloned endolysin gene, encoded by bacteriophage Ef11, was expressed, and the resulting gene product was purified to electrophoretic homogeneity. A seven-day course of treatment with the endolysin resulted in the elimination of the infection to below culturally detectable levels, and the abatement of symptoms to near normal levels. Furthermore, during the endolysin treatment, the patient experienced no untoward reactions. The present report demonstrates the effectiveness of an endolysin as a novel modality in managing a recalcitrant infection that could not be controlled by conventional antibiotic therapy.
慢性前列腺炎(CP)是前列腺常见的炎症性疾病,据估计全球男性人口中有2%-10%受其影响。它可表现为会阴、耻骨上或下背部疼痛以及排尿症状,可伴有反复细菌感染[慢性细菌性前列腺炎(CBP)],或在无细菌感染证据的情况下出现[慢性盆腔疼痛综合征(CPPS)]。在此,我们报告了首例成功使用噬菌体衍生的溶菌酶(内溶素)治疗并治愈一名39岁CBP患者疾病的案例。对该患者前列腺分泌物和精液样本的细菌学分析显示存在慢性前列腺感染,支持CBP的诊断。该患者的菌株对多种抗生素耐药,且在治疗过程中对其他抗生素也产生了耐药性。此前使用多疗程抗生素、噬菌体、益生菌和免疫刺激治疗均未能实现长期根除感染或持久缓解症状。由噬菌体Ef11编码的克隆内溶素基因被表达,所得基因产物经纯化达到电泳纯。用内溶素进行为期七天的治疗后,感染消除至培养检测不到的水平,症状减轻至接近正常水平。此外,在内溶素治疗期间,患者未出现不良反应。本报告证明了内溶素作为一种新型治疗手段,对传统抗生素治疗无法控制的顽固性感染具有有效性。